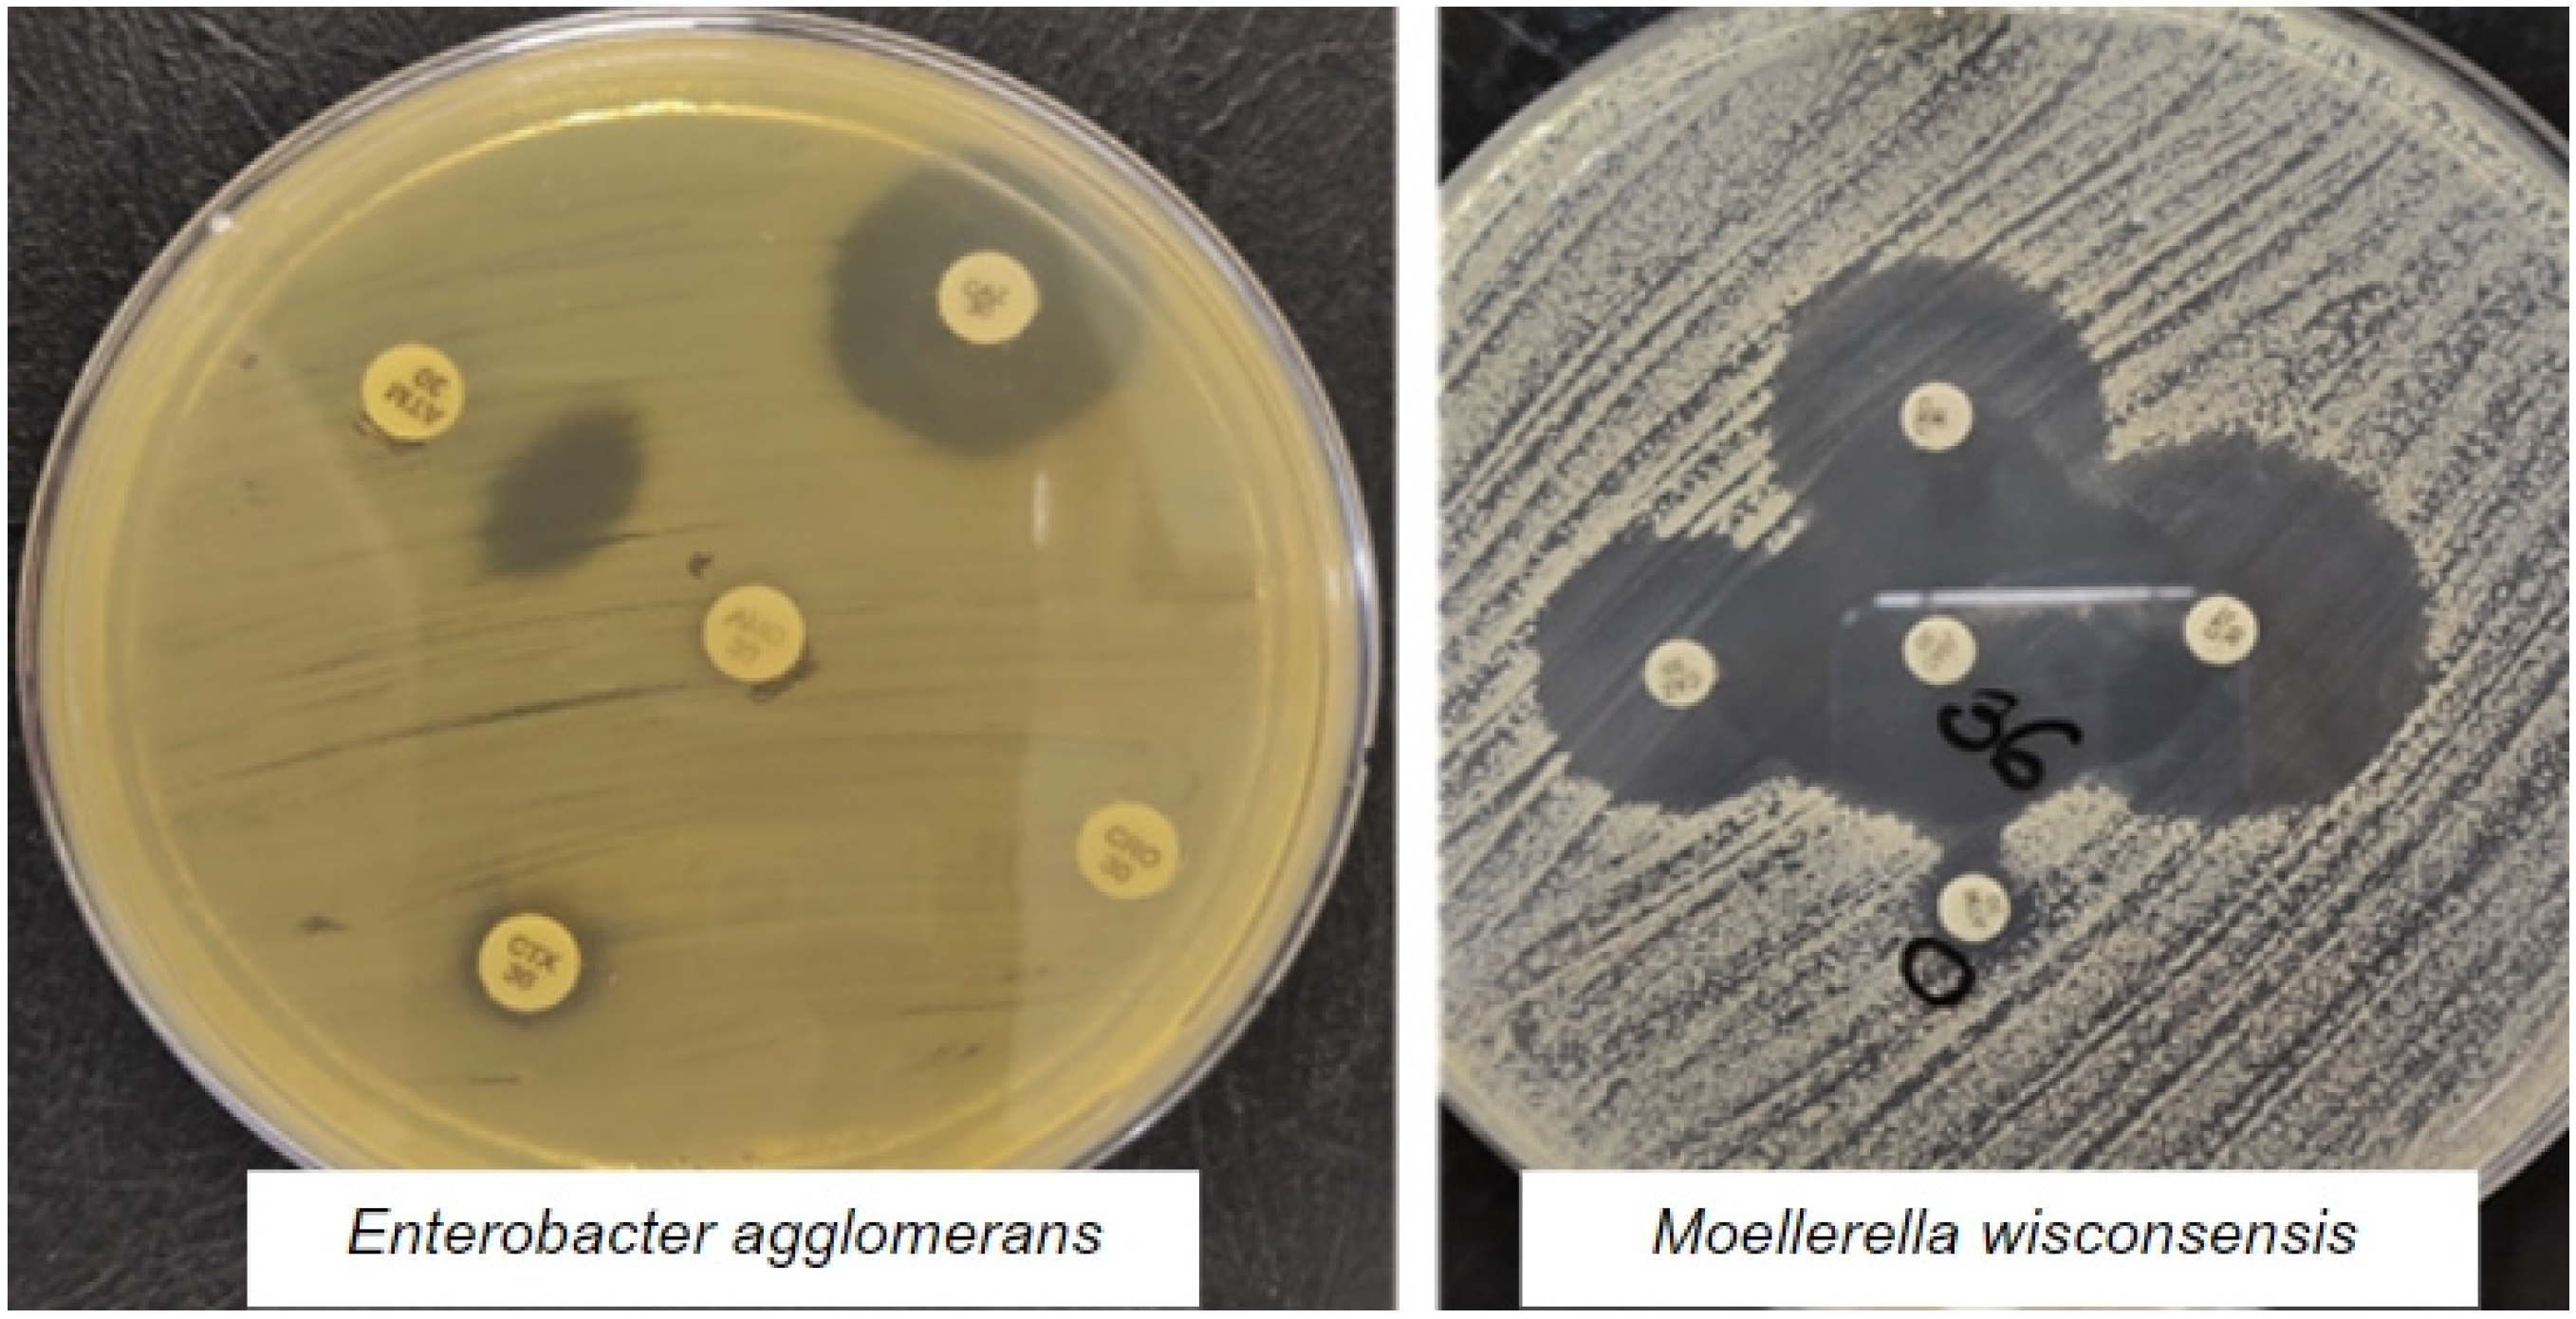
Animals 13 01147 g001

Resistance Profile of Bovine Mastitis Isolates, Presence of the mecA Gene and Identification of ESBL Producing Strains from Small Rural Dairy Properties
Abstract
Simple Summary
Abstract
1. Introduction
2. Material and Methods
2.1. Criterion for Inclusion of Rural Properties, Origin and Number of Samples
2.2. Sample Collection
2.3. Culture, Isolation and Phenotypic Characterization of Samples
2.4. Antimicrobial Sensitivity Tests
2.5. Phenotypic Test for Detection of Extended Spectrum Beta-Lactamase (ESBL) Producing Strains
2.6. Molecular Identification of Staphylococcus aureus Isolates
2.7. mecA Gene Research
3. Results
4. Discussion
5. Conclusions
Author Contributions
Funding
Institutional Review Board Statement
Informed Consent Statement
Data Availability Statement
Acknowledgments
Conflicts of Interest
References
- Algharib, S.; Dawood, A.; Xie, S. Nanoparticles for Treatment of bovine Staphylococcus aureus mastites. J. Drug Deliv. 2020, 27, 292–308. [Google Scholar] [CrossRef] [PubMed]
- Quintão, A. IBGE: Produção de Leite Cresce 1.8% no 1T em Relação a 2020. MilkPoint. 2021. Available online: https://www.milkpoint.com.br/noticias-e-mercado/panorama-mercado/ibge-producao-cresce-18-no-primeiro-tri-de-2021-225841 (accessed on 8 September 2022).
- Dea, M.; Abraham, R.; Sahibzada, S.; Lee, T.; Jordan, D.; Laird, T.; Pang, S.; Buller, N.; Stegger, M.; Coombs, G.; et al. Antimicrobial resistance and genomic insights into bovine mastites-associated Staphylococcus aureus in Australia. Vet. Microbiol. 2020, 250, 108850. [Google Scholar]
- Yapicier, O.; Sababoglu, E.; Ozturk, D.; Turutoglus, H.; Pehlivanoglu, F.; Kaya, M. Lancefield Classification and antimicrobial resistance of hemolytic Streptococce isolated from bovine mastitis. Vet. Ital. 2021, 57, 41–47. [Google Scholar]
- Ashraf, A.; Imran, M. Causes, types, etiological agents, prevalence, diagnosis, treatment, prevention, effects on human health and future aspects of bovine mastites. Anim. Health Res. Rev. 2020, 21, 36–49. [Google Scholar] [CrossRef]
- Nader, T.T.; Coppede, J.S.; Taleb-Contini, S.H.; Amaral, L.A.; Pereira, A.M.S. Atividade antibiofilme de substâncias de Croton urucurana em Staphylococcus aureus isolado de mastite bovina. Pesq. Vet. Bras. 2018, 38, 1713–1719. [Google Scholar] [CrossRef]
- Israel, L.F.S.; Rabello, R.F.; Domingos, S.C.B.; Medeiros, L.S. Biofilme production by Staphylococcus chromogenes isolated from milk samples from bovine with mastites. Arq. Bras. Med. Vet. Zootec. 2018, 70, 1943–1949. [Google Scholar] [CrossRef]
- Santos, W.B.R. Mastite bovina: Uma revisão. Colloq. Agrar. 2017, 13, 301–314. [Google Scholar] [CrossRef]
- Costa, H.N.; Molina, L.R.; Lage, C.; Malacco, V.M.R.; Filho, E.J.F.; Carvalho, A.U. Estimativa da perda de produção leiteira em vacas mestiças Holandês × Zebu com mastite subclínica baseada em duas metodologias de análise. Arq. Bras. Med. Vet. Zootec. 2017, 69, 579–586. [Google Scholar] [CrossRef]
- Haenni, A.; Lupo, A.; Madec, J. Antimicrobial resistance in Streptococcus spp. Microbiol. Spectr. 2018, 6, 1–25. [Google Scholar] [CrossRef]
- Shin, M.; Mun, D.; Choi, H.; Kim, S.; Payne, S.; Kim, Y. Identification of a new antimicrobial agente Against bovine mastites-causing Staphylococcus aureus. J. Agric. Food Chem. 2021, 69, 9968–9978. [Google Scholar] [CrossRef]
- Molineri, A.; Camussone, C.; Zbrun, M.; Archilla, G.; Cristiani, M.; Neder, V.; Calvinho, L.; Signorini, M. Antimicrobial resistance of Staphylococcus aureus isolated from bovine mastitis: Systematic review and meta-analyisis. Prev. Vet. Med. 2021, 188, 105261. [Google Scholar] [CrossRef]
- Koneman, E.W.; Allen, S.D.; Janda, W.M.; Schreckenberger, P.C.; Winn, W.C., Jr. Diagnóstico Microbiológico: Texto e Atlas Colorido, 5th ed.; MEDSI: São Paulo, SP, Brazil, 2001; 1465p. [Google Scholar]
- Quinn, P.J.; Markey, B.K.; Cater, M.E.; Donnely, W.J.; Leonar, F.C. Microbiologia Veterinária e Doenças Infecciosas; Artmed: Porto Alegre, RS, Brazil, 2005; 512p. [Google Scholar]
- Schwar, S.; Silley, P.; Simjee, S.; Woodford, N.; van Duijkeren, E.; Johnson, A.P.; Gaastra, W. Editorial: Assessing the antimicrobial susceptibility of bacteria obtained from animals. J. Antimicrob. Chemother. 2010, 65, 601–604. [Google Scholar] [CrossRef] [PubMed]
- Brun-Buisson, C.; Philippon, A.; Ansquer, M.; Legrand, P.; Montravers, F.; Duval, J. Transferable enzymatic resistance to third-generation cephalosporins during nosocomial outbreak of multiresistant Klebsiella pneumoniae. Lancet 1987, 330, 302–306. [Google Scholar] [CrossRef] [PubMed]
- Martineau, F.; Picard, F.J.; Roy, P.H.; Ouellette, M.; Bergeron, M.G. Species-specific and ubiquitous-DNA-based assays for rapid identification of Staphylococcus aureus. J. Clin. Microbiol. 1998, 6, 618–623. [Google Scholar] [CrossRef]
- Murakami, K.; Minamide, W.; Wada, K.; Nakamura, E.; Teraoka, H.; Watanabe, S. Identification of methicillin-resistant strains of staphylococci by polymerase chain reaction. J. Clin. Microbiol. 1991, 29, 2240–2244. [Google Scholar] [CrossRef] [PubMed]
- Thongratsakul, S.; Usui, M.; Higuchi, H.; Takahashi, T.; Sato, Y.; Poolkhet, C.; Tamura, Y. Prevalence and characterization of Staphylococcus aureus isolated in raw milk from cows in Hokkaido, Japan. Trop. Anim. Health Prod. 2020, 52, 1631–1637. [Google Scholar] [CrossRef]
- Salauddin, M.; Akter, M.; Hossain, M.; Nazir, K.; Noreddin, A.; Zowalaty, M. Molecular Detection of Multidrug resistant Staphylococcus aureus isolated from bovine mastitis milk in Bangladesh. Vet. Sci. 2020, 7, 36. [Google Scholar] [CrossRef]
- Taniguchi, T.; Latt, K.M.; Tarigan, E.; Yano, F.; Sato, H.; Minamino, T.; Misawa, N. A 1-Year Investigation of Extended-spectrum Beta-lactamase-producing Escherichia coli and Klebsiella pneumoniae Isolated from bovine mastitis at a large-scale dairy farm in Japan. Microb. Drug. Resist. 2021, 27, 1450–1454. [Google Scholar] [CrossRef]
- Ahmadi, E.; Mardani, K.; Amiri, A. Molecular detection and antimicrobial resistance patterns of shiga toxigeni Escherichia coli isolated from bovine subclinical mastitis milk Samples in Kurdistan, Iran. Razi Inst. 2020, 75, 169–177. [Google Scholar]
- Saidani, M.; Messadi, L.; Soudani, A.; Daaloul-Jedidi, M.; Châtre, P.; Chehida, F.B.; Mamlouk, A.; Mahjoub, W.; Madec, J.; Haenni, M. Epidemiology, antimicrobial resistance, and Extended-Spectrum Beta-Lactamase-Producing Enterobacteriaceae in Clinical bovine mastitis in Tunisia. Microb. Drug. Resist. 2018, 24, 1242–1248. [Google Scholar] [CrossRef]
- Carvalho, D.; Kunert-Filho, H.C.; Simoni, C.; De Moraes, L.B.; Furian, T.Q.; Borges, K.A.; Breunig, J.G.; Medeiros, L.P.; Kobayashi, R.K.T.; Tagliari, K.C.; et al. Antimicrobial susceptibility and detection of virulence-associated genes of Escherichia coli and Salmonella spp. isolated from domestic pigeons (Columba livia) in Brazil. Folia Microbiol. 2020, 65, 735–745. [Google Scholar] [CrossRef] [PubMed]
- Sheet, O.H.; Grabowski, N.T.; Klein, G.; Reich, F.; Abdulmawjood, A. Characterisation of mecA gene negative Staphylococcus aureus isolated from bovine mastitis milk from Northern Germany. Folia Microbiol. 2019, 64, 845–855. [Google Scholar] [CrossRef] [PubMed]
- Frey, Y.; Rodriguez, J.P.; Thomann, A.; Schwendener, S.; Perrete, V. Genetic characterization of antimicrobial resistance in coagulase-negative staphylococci from bovine mastitis milk. J. Dairy Sci. 2013, 96, 2247–2257. [Google Scholar] [CrossRef] [PubMed]
- Sheet, O.H. Molecular detection of mecA gene in methicillin-resistant Staphylococcus aureus isolated from dairy mastitis in Nineveh governorate, Iraq. Iraqi J. Vet. Sci. 2022, 36, 939–943. [Google Scholar] [CrossRef]
| Microorganisms | Milk | Milkers’ Hand | Milking Machines | N° | % |
|---|---|---|---|---|---|
| CoNS | 12 | - | 2 | 14 | 20 |
| CoPS Non-aureus | 1 | 1 | 7 | 9 | 12.85 |
| Staphylococcus aureus | 9 | 3 | 4 | 16 | 22.85 |
| Escherichia coli | 3 | - | 1 | 4 | 5.71 |
| Enterobacter aerogenes | - | - | 1 | 1 | 1.44 |
| Enterobacter agglomerans | 1 | 1 | 1 | 3 | 4.28 |
| Kluyvera ascorbata | 2 | - | - | 2 | 2.85 |
| Moellerella wisconsensis | - | - | 1 | 1 | 1.44 |
| No growing | 17 | - | 3 | 20 | 28.58 |
| Total | 45 | 5 | 20 | 70 | 100 |
| Microorganisms | Milk | Milkers’ Hand | Milking Machines | N° | % |
|---|---|---|---|---|---|
| CoNS | 9 | 3 | 8 | 20 | 31 |
| CoPS-Non-aureus | 4 | - | - | 4 | 6.45 |
| Staphylococcus aureus | 3 | - | - | 3 | 4.53 |
| Escherichia coli | - | - | 4 | 4 | 6.45 |
| Citrobacter koseri | - | - | 1 | 1 | 1.60 |
| Kluyvera ascorbata | - | 1 | 1 | 2 | 3.22 |
| Moellerella wisconsensis | - | - | 1 | 1 | 1.60 |
| Serratia marcescens | - | 1 | - | 1 | 1.60 |
| No growing | 19 | - | 7 | 26 | 43.55 |
| Total | 35 | 5 | 22 | 62 | 100 |
| Microorganisms | Milk | Milkers’ Hand | Milking Machines | N° | % |
|---|---|---|---|---|---|
| CoNS | 10 | 1 | - | 11 | 16.41 |
| CoPS-Non-aureus | 4 | - | - | 4 | 5.97 |
| Staphylococcus aureus | 1 | - | 1 | 2 | 2.98 |
| Escherichia coli | - | 3 | 10 | 13 | 19.40 |
| Enterobacter aerogenes | - | - | 1 | 1 | 1.50 |
| Hafnia alvei | - | - | 1 | 1 | 1.50 |
| No growing | 27 | 1 | 7 | 35 | 52.24 |
| Total | 42 | 5 | 20 | 67 | 100 |
| Bacterial Resistance | |||||
|---|---|---|---|---|---|
| Antibiotics | Milk | Milkers’ Hand | Milking Machines | N° | % |
| Amoxicillin + clavulanate | 0 | 1 | 5 | 6 | 3.10 |
| Amikacin | 0 | 0 | 6 | 6 | 3.10 |
| Amoxicillin | 2 | 3 | 13 | 18 | 9.33 |
| Cefoxitin | 4 | 3 | 14 | 21 | 10.89 |
| Clindamycin | 4 | 6 | 21 | 31 | 16.06 |
| Chloramphenicol | 0 | 2 | 10 | 12 | 6.21 |
| Ceftiofur | 1 | 0 | 7 | 8 | 4.15 |
| Doxycycline | 1 | 0 | 2 | 3 | 1.55 |
| Erythromycin | 2 | 4 | 17 | 23 | 11.92 |
| Meropenem | 0 | 0 | 2 | 2 | 1.04 |
| Oxacillin | 6 | 5 | 22 | 33 | 17.10 |
| Rifampicin | 5 | 5 | 20 | 30 | 15.55 |
| TOTAL | 25 | 29 | 139 | 193 | 100 |
| Samples | Antibiotics and Resistance | Presence of the mecA Gene | ||||||||||||
|---|---|---|---|---|---|---|---|---|---|---|---|---|---|---|
| AMC | AMI | AMO | CFO | CLI | CLO | CTF | DOX | ERI | MER | OXA | RIF | |||
| Animals | Identification | |||||||||||||
| 1 | S. aureus | S | S | S | S | S | S | S | S | S | S | R | R | P |
| 3 | CoNS | S | S | S | S | S | S | S | S | S | S | S | S | P |
| 13 | CoNS | S | S | S | S | S | S | S | S | S | S | R | S | P |
| 14 | CoNS | S | S | S | S | S | S | S | S | S | S | S | S | P |
| Milking Machines | ||||||||||||||
| After 4/2 | S. aureus | S | R | S | R | I | R | I | I | S | S | R | I | P |
| After 5/1 | S. aureus | S | S | I | S | R | S | S | S | R | S | R | R | P |
| Samples | Antibiotics and Resistance | Presence of the mecA Gene | ||||||||||||
|---|---|---|---|---|---|---|---|---|---|---|---|---|---|---|
| AMC | AMI | AMO | CFO | CLI | CLO | CTF | DOX | ERI | MER | OXA | RIF | |||
| Animals | Identification | |||||||||||||
| 70 | CONS | S | S | S | S | R | S | S | S | R | S | R | S | P |
| 77 | CONS | S | S | S | R | S | S | S | S | S | S | S | S | P |
| 78 | CONS | I | S | R | R | R | S | S | S | R | S | R | R | P |
| 80 | CONS | S | S | S | S | R | S | S | S | R | S | R | R | P |
| Hands | ||||||||||||||
| 9 | CONS | I | R | I | R | R | S | R | S | S | S | R | R | P |
Disclaimer/Publisher’s Note: The statements, opinions and data contained in all publications are solely those of the individual author(s) and contributor(s) and not of MDPI and/or the editor(s). MDPI and/or the editor(s) disclaim responsibility for any injury to people or property resulting from any ideas, methods, instructions or products referred to in the content. |
© 2023 by the authors. Licensee MDPI, Basel, Switzerland. This article is an open access article distributed under the terms and conditions of the Creative Commons Attribution (CC BY) license (https://creativecommons.org/licenses/by/4.0/).
Share and Cite
Fazoli, K.G.Z.; Rey, L.M.R.; Rúbio, K.A.J.; Garcia Souza, M.A.; Oliveira, H.M.d.S.; Ribeiro, D.C.; Pereira, K.R.d.J.D.; Kawamo, D.M.; Gomes, T.K.A.; Silva, I.B.d.; et al. Resistance Profile of Bovine Mastitis Isolates, Presence of the mecA Gene and Identification of ESBL Producing Strains from Small Rural Dairy Properties. Animals 2023, 13, 1147. https://doi.org/10.3390/ani13071147
Fazoli KGZ, Rey LMR, Rúbio KAJ, Garcia Souza MA, Oliveira HMdS, Ribeiro DC, Pereira KRdJD, Kawamo DM, Gomes TKA, Silva IBd, et al. Resistance Profile of Bovine Mastitis Isolates, Presence of the mecA Gene and Identification of ESBL Producing Strains from Small Rural Dairy Properties. Animals. 2023; 13(7):1147. https://doi.org/10.3390/ani13071147
Chicago/Turabian StyleFazoli, Kawany Gabrieli Zanetti, Laisa Marina Rosa Rey, Kariny Aparecida Jardim Rúbio, Mateus Augusto Garcia Souza, Halison Murilo da Silva Oliveira, Débora Cristina Ribeiro, Kelly Regina de Jesus Duarte Pereira, Denise Miyuki Kawamo, Thays Karollyni Amaral Gomes, Isadora Brito da Silva, and et al. 2023. "Resistance Profile of Bovine Mastitis Isolates, Presence of the mecA Gene and Identification of ESBL Producing Strains from Small Rural Dairy Properties" Animals 13, no. 7: 1147. https://doi.org/10.3390/ani13071147
APA StyleFazoli, K. G. Z., Rey, L. M. R., Rúbio, K. A. J., Garcia Souza, M. A., Oliveira, H. M. d. S., Ribeiro, D. C., Pereira, K. R. d. J. D., Kawamo, D. M., Gomes, T. K. A., Silva, I. B. d., Santos, I. C. d., Ferreira, L. R. d. P., Rahal, I. L., Valle, J. S. d., Ruiz, S. P., Faria, M. G. I., Gazim, Z. C., Piau Junior, R., & Gonçalves, D. D. (2023). Resistance Profile of Bovine Mastitis Isolates, Presence of the mecA Gene and Identification of ESBL Producing Strains from Small Rural Dairy Properties. Animals, 13(7), 1147. https://doi.org/10.3390/ani13071147

